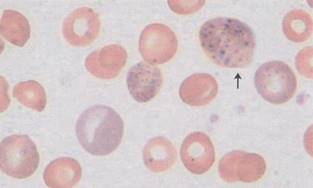
02d91f05592f6ac1fef718a31389fca8.png

高频考题
1、在临床检验质量控制中,相当于评价诊断试验灵敏度的指标是
A、假失控概率B、误差检出概率
C、在控预测值
D、失控预测值
E、失控效率
【答案】B
【解析】在临床检验质量控制中,误差检出概率(Ped)相当于评价诊断试验灵敏度的指标。
它表示在存在额外分析误差的情况下,质控方法能够正确识别并发出失控信号的概率。
理想的Ped值接近1.00,意味着几乎可以100%地检出有误差的分析批。
因此,选择B:误差检出概率作为本题答案。
2、关于AIDS的叙述,错误的是
A、HIV病毒是DNA病毒B、可通过性接触和吸毒传染
C、发病表现为机体免疫功能受损
D、易并发机会感染
E、易并发肿瘤
【答案】A
【解析】1、正确答案:A
2、答案解析:HIV病毒是RNA病毒,属于反转录病毒科慢病毒亚科,其基因组为单股正链RNA,依赖反转录酶将RNA逆转录为DNA。
病毒颗粒呈球形,核心含RNA、反转录酶及核衣壳蛋白,外包脂质膜,表面镶嵌gp120与gp41糖蛋白,其中gp120可特异性结合宿主细胞CD4受体。
因此,HIV并非DNA病毒,选项A错误。
3、假定血糖在常规实验室20天测定的质控结果的均数为5.5mmol/L,标准差为0.5mmol/L,如果采用22S规则,其失控制界限为
A、下限为5mmol/L,上限为6mmol/LB、下限为4mmoI/L,上限为7mmol/L
C、下限为4.5mmol/L,上限为6.5mmol/L
D、下限为4mmoI/L,上限为6.5mmol/L
E、下限为3.5mmol/L,上限为7.5mmol/L
【答案】C
【解析】1、正确答案:C
2、答案解析:根据室内质量控制原则,采用22S规则时,失控界限为均数±2倍标准差。
本题均数为5.5 mmol/L,标准差为0.5 mmol/L,故控制限为5.5±1.0,即下限4.5 mmol/L,上限6.5 mmol/L。
该范围对应±2s质控界限,符合正态分布下的质量控制标准。
4、初级胆汁酸的合成部位是
A、肾B、肝
C、心脏
D、小肠
E、脂肪组织
【答案】B
【解析】胆汁酸在肝细胞内由胆固醇转化生成,成年人每日合成400~600mg,均存在胆汁中,在肝细胞内合成的叫初级胆汁酸,其主要成分有胆酸、鹅脱氧胆酸。
5、下列不是由葡萄球菌引起的疾病是
A、细菌性心内膜炎B、食物中毒
C、肾小球肾炎
D、败血症
E、假膜性肠炎
【答案】C
【解析】本题答案选:C:肾小球肾炎;
解析:肾小球肾炎通常是由A组链球菌感染引起的,而非葡萄球菌所致。
葡萄球菌可以引起包括皮肤感染、食物中毒、败血症、假膜性肠炎在内的多种疾病。
因此,选择C作为错误选项是正确的。
6、患者男性,28岁。因全身大片瘀斑、臂出血难止前来就诊。实验室检查:WBC3.5×109/L,PLT40×109/L,骨髓涂片可见大量幼稚细胞,Auer小体易见。该患者最有可能是
A、M1B、M2
C、M3
D、M4
E、M5
【答案】C
【解析】1、正确答案:C:M3
2、答案解析:该患者表现为全身瘀斑、出血倾向,实验室检查显示血小板减少(PLT 40×109/L)及白细胞减少(WBC 3.5×109/L),骨髓涂片见大量幼稚细胞且Auer小体易见,符合急性早幼粒细胞白血病(APL,即FAB分型中的M3型)的典型特征。
M3型以异常早幼粒细胞增生为主,常伴有多颗粒或微颗粒变型,胞质富含嗜天青颗粒,Auer小体常见,甚至呈柴捆状。
此类细胞可释放促凝物质,导致弥散性血管内凝血(DIC),临床易出现严重出血表现,与该患者症状相符。
7、下列关于质控品基本要求的说法,错误的是
A、无或很小的基质效应B、最好来源于小牛或马血
C、成分稳定
D、添加剂及调制物少
E、瓶子间变异小
【答案】B
【解析】质控品的基本要求包括:
1. 无或很小的基质效应:确保质控品的基质与实际样本相似,以减少基质对检测结果的影响。
2. 成分稳定:保证质控品在储存和使用过程中成分不变,避免影响检测结果的准确性。
3. 瓶子间变异小:确保不同小瓶间的质控品具有相似的性能,提高结果的一致性。
4. 添加剂及调制物少:减少可能干扰检测结果的物质,保持质控品的纯净度。
因此,错误的选项是 B:最好来源于小牛或马血。
通常建议质控品来源于与临床样本相匹配的人血,以确保最佳的基质匹配性和适用性。
8、传染性单核细胞增多症可出现的表现中错误的是
A、发热B、淋巴结肿大
C、嗜异性凝集试验阴性
D、淋巴细胞比例增加
E、异型淋巴细胞比例超过10%
【答案】C
【解析】选项C:“嗜异性凝集试验阴性”表述错误。
传染性单核细胞增多症患者的血清中会存在嗜异性抗体,这种抗体在起病后第1~2周开始出现,并在第2~3周达到高峰,持续时间可达3~6个月或更长。
因此,对于该疾病,嗜异性凝集试验通常呈现阳性反应,而非阴性。
9、不能从脑脊液标本中分离到的病毒是
A、柯萨奇病毒B、肝炎病毒
C、肠道病毒
D、ECHO病毒
E、腮腺炎病毒
【答案】B
【解析】本题正确答案为B:肝炎病毒。
肝炎病毒主要感染肝脏,不从脑脊液标本中分离出来。
其他选项如柯萨奇病毒、肠道病毒、ECHO病毒和腮腺炎病毒都可以在脑脊液标本中被检测到或分离出来。
10、不属于一期止血缺陷筛查试验的是
A、血块回缩试验B、血小板计数
C、纤维蛋白原含量测定
D、出血时间
E、毛细血管脆性试验
【答案】C
【解析】纤维蛋白原含量测定不是一期止血缺陷的筛查试验。
一期止血缺陷主要通过评估血管壁和血小板功能来筛查,包括血块回缩试验、血小板计数、出血时间和毛细血管脆性试验。
而纤维蛋白原含量测定主要用来评估凝血因子的功能,适用于评估凝血过程中的第二阶段是否正常,因此不包含在一期止血缺陷的筛查试验中。
11、与纤溶酶原具有高度同源性的载脂蛋白是
A、ApoAⅠB、ApoE
C、ApoB100
D、ApoⅢ
E、Apo(a)
【答案】E
【解析】本题考查的是脂蛋白(a)[Lp(a)]中关键成分Apo(a)的相关知识。
Apo(a)与纤溶酶原具有高度同源性,这意味着它们在结构上有显著的相似性。
这一特点使得Apo(a)能够与纤溶酶原竞争结合纤维蛋白,从而影响纤维蛋白的降解过程。
此外,Lp(a)的形成方式也是关键信息:一分子的Apo B100与Apo(a)通过单个双硫键连接,形成了Lp(a)这一复合物。
因此,本题的正确答案为E:Apo(a),因为它直接体现了与纤溶酶原的同源性和在脂蛋白(a)结构中的重要作用。
12、比较两组不同量纲资料变异程度的指标是
A、变异系数(CV)B、方差(S2)
C、相关系数(r)
D、标准差(SD)
E、极差(R)
【答案】A
【解析】比较两组不同量纲资料的变异程度时,应选用变异系数(CV)。
变异系数作为相对量指标,不依赖于量纲,可以有效比较不同单位或显著差异均值数据的变异度。
其他选项如方差、标准差、相关系数和极差虽能反映数据的离散程度,但它们都是绝对量指标,不适合直接比较不同量纲或显著不同均值的数据变异程度。
13、属于再生障碍性贫血特点的是
A、病程一般在2年左右B、网织红细胞在1%~5%
C、骨髓非造血细胞增高,但不超过70%
D、HbF明显增高
E、免疫功能受损严重
【答案】E
【解析】1、正确答案:E
2、答案解析:再生障碍性贫血是由于多种因素导致造血干细胞数量减少和/或功能异常,引起全血细胞减少的获得性疾病。
其发病机制与造血微环境损伤及免疫介导的骨髓抑制密切相关。
临床表现为进行性贫血、出血倾向及反复感染,其中免疫功能受损严重是重要特征之一。
骨髓象显示增生减低,非造血细胞比例增高(可超过70%),造血组织容积比显著降低。
网织红细胞通常低于1%,HbF一般不升高,病程可持续数年。
14、PAgT增高可见于
A、妊娠高血压综合征B、静脉血栓形成
C、肺梗死
D、口服避孕药
E、以上均是
【答案】E
【解析】1、正确答案:E、以上均是
2、答案解析:PAgT增高反映血小板聚集功能增强,主要见于高凝状态、血栓前状态及血栓性疾病。
本题中所列选项均为临床常见的促进血小板聚集的病理或生理状态:妊娠高血压综合征因血管内皮损伤及高凝倾向导致PAgT升高;
静脉血栓形成和肺梗死属于血栓性疾病,伴有血小板活化;
口服避孕药可引起凝血因子增加及血小板反应性增强。
因此,上述情况均可出现PAgT增高,故正确答案为E。
15、不属于红细胞破坏过多引起的贫血是
A、血红蛋白病B、骨髓增生异常综合征
C、遗传性球形细胞增多症
D、G-6-PD缺乏症
E、冷凝集素综合征
【答案】B
【解析】答案选项B:“骨髓增生异常综合征”不属于红细胞破坏过多引起的贫血。
红细胞破坏过多的贫血常见原因包括血红蛋白病(如镰状细胞贫血)、遗传性球形细胞增多症、G-6-PD缺乏症以及冷凝集素综合征等。
这些疾病通常与红细胞的形态、功能异常或者特定环境因素(如感染)导致的红细胞提前破坏有关。
而骨髓增生异常综合征则是一种造血功能紊乱疾病,其特征在于骨髓中血细胞发育异常,而不是直接由红细胞破坏过多引起。
因此,正确答案选B。
16、将胆固醇从肝外转运到肝进行代谢的脂蛋白是
A、CMB、Lp(a)
C、HDL
D、LDL
E、VLDL
【答案】C
【解析】HDL从周围组织得到胆固醇并在卵磷脂胆固醇酰基转移酶(LCAT)作用下转变成胆固醇酯后,直接将其运送到肝,再进一步代谢,起到清除周围组织胆固醇的作用。
17、不能经糖异生途径合成葡萄糖的物质是
A、γ-磷酸甘油B、丙酮酸
C、乳酸
D、乙酰CoA
E、生糖氨基酸
【答案】D
【解析】乙酰CoA不能经糖异生途径合成葡萄糖。
在正常生理条件下,乙酰CoA主要通过脂肪酸β氧化产生能量,或转化为酮体供其他组织利用,而非参与葡萄糖的合成。
因此,选项D正确。
18、正态分布μ±1.96σ的面积占总面积的
A、95.00%B、95.45%
C、68.27%
D、98.00%
E、99.00%
【答案】A
【解析】在正态分布中,μ±1.96s的面积占总面积的95%,因此正确答案是A:95.00%。
这一范围意味着大约95%的数据点会落在均值(μ)加减1.96个标准差(s)的区间内。
19、关于医务人员合理收取费用的说法,正确的是
A、私自收受红包B、收取一定加急费用
C、利用上班空闲时间为外地就诊患者挂号,插队检查,收取患者一定的费用
D、院内会诊,可收取一定费用
E、院际会诊,可收取一定费用
【答案】E
【解析】选项E“院际会诊,可收取一定费用”是正确的,因为院际会诊涉及专业医疗资源的跨地区共享,合理收取费用体现了对医疗服务提供者劳动价值的尊重以及对运营成本的补偿。
其他选项如私自收受红包、收取一定加急费用、利用上班空闲时间为外地就诊患者挂号并收取费用等,均违反了医疗伦理和法律法规,损害了患者的权益,因此不正确。
20、男性,35岁。近2年身体虚弱无力,食欲缺乏,消瘦,皮肤黏膜均有色素沉着,身体抵抗力下降。实验室检查:血糖降低,血钠降低,血钾、血钙升高,皮质醇降低,血浆ACTH降低,ACTH兴奋试验为延迟反应。该患者最可能患何种疾病
A、原发性肾上腺皮质功能减退症B、肾上腺皮质腺瘤
C、肾上腺皮质腺癌
D、异源性ACTH综合征
E、继发性肾上腺皮质功能减退症
【答案】E
【解析】1、正确答案:E
2、答案解析:患者表现为乏力、消瘦、食欲减退、低血糖、低血钠、高血钾、高血钙,血浆ACTH降低、皮质醇降低,且ACTH兴奋试验呈延迟反应,提示肾上腺皮质功能低下继发于促激素不足。
结合ACTH与皮质醇均降低,符合继发性肾上腺皮质功能减退症,病因多为下丘脑-垂体轴功能障碍导致ACTH分泌减少。
21、胸腔黏稠样积液常见于( )。
A、白血病B、肝硬化
C、恶性间皮瘤
D、阿米巴脓肿
E、结核
【答案】C
【解析】恶性间皮瘤时胸腔积液常呈现为黏稠样状态。
22、代表送检标本的唯一性标志并不可少的内容是
A、姓名B、性别
C、年龄
D、科室
E、诊断
【答案】A
【解析】在送检标本中,代表送检标本唯一性标志并不可少的内容是姓名。
姓名作为个体身份的唯一标识,确保了每一份送检标本能够准确对应到特定的患者,从而保证检验结果与患者的医疗记录相匹配,确保诊断和治疗的准确性。
23、制备抗体酶结合物的常用方法是
A、戊二醛交联法B、糖原染色法
C、免疫印迹法
D、酶偶联测定法
E、捕获竞争法
【答案】A
【解析】制备抗体酶结合物通常采用的方法是戊二醛交联法。
这种方法利用戊二醛作为双功能试剂,能够使酶与蛋白质或其他抗原通过其氨基偶联,实现酶与抗体或抗原的有效结合。
因此,正确答案是A:戊二醛交联法。
24、免疫定性测定时,应设置一个弱阳性的质控品,其理由是
A、提高检测结果的灵敏度B、更灵敏的发现假阴性
C、更灵敏的发现非特异性反应
D、更灵敏的发现交叉反应
E、更灵敏的发现假阳性
【答案】B
【解析】1、正确答案:B
2、答案解析:在定性免疫测定中,设置弱阳性室内质控品的主要目的是监控检测系统的分析灵敏度和检测下限的稳定性。
弱阳性质控品接近方法的检出限,可敏感反映试剂或仪器性能下降导致的检测能力减退。
当检测系统灵敏度降低时,可能出现假阴性结果,而弱阳性质控若出现阴性反应,即可及时发现该异常。
因此,弱阳性质控能更灵敏地识别潜在的假阴性风险,确保临床报告的准确性。
25、室间质量评价活动中,偏倚的计算公式为
A、(测定结果-靶值)/靶值×100%B、(测定结果-均值)/标准差
C、测定结果/均值×100%
D、测定结果-靶值
E、测定结果-均值
【答案】A
【解析】偏倚(Bias%)通过公式(测定结果-靶值)/靶值×100%来计算,旨在衡量测定结果与靶值之间的差异相对于靶值的百分比。
这一指标用于评估实验室检测结果的准确性,帮助识别系统误差。
26、对自身免疫性溶血性贫血患者,应首选的输血成分是( )。
A、全血B、浓缩红细胞
C、洗涤红细胞
D、少白血病的红细胞
E、红细胞加血浆
【答案】C
【解析】自身免疫性溶血性贫血患者选择输血成分时,应优先考虑洗涤红细胞。
洗涤红细胞,最常用于因输血而发生严重过敏的患者。
27、不会引起红细胞代偿性增多的是( )。
A、法洛四联症B、真性红细胞增多症
C、慢性肺心病
D、新生儿
E、高山居民
【答案】B
【解析】原发性红细胞增多:如真性红细胞增多症、良性家族性红细胞增多症等。而选项B“真性红细胞增多症”并非由缺氧引起的代偿性反应,而是由于体内骨髓异常增生所导致的红细胞数量显著增多,不属于红细胞代偿性增多的范畴。
其他选项如法洛四联症、慢性肺心病、新生儿及高山居民的情况中,红细胞增多是机体为了应对低氧环境而发生的代偿性反应,符合红细胞代偿性增多的定义。
28、关于红细胞沉降率的影响因素正确的是( )。
A、红细胞数越多血沉越快B、血浆纤维蛋白原增多血沉加快
C、红细胞表面带正电荷血沉减慢
D、球蛋白可增加红细胞表面负电荷
E、球形红细胞易形成缗钱状
【答案】B
【解析】
血浆纤维蛋白原增加,血沉增快。
29、多尿不见于( )情况。
A、饮水过多、食用含水分高的食物B、服用有利尿作用的食品,如咖啡
C、静脉输注液体过多
D、精神紧张、癔症等
E、严重损伤
【答案】E
【解析】这道题目考核的知识点是“多尿的常见原因”。
多尿是指24小时尿总量成人超过2500ml,儿童超过3L者。
(1)生理性多尿:可见于:
①饮水过多或食用含水分高的食物;
②服用有利尿作用的食品,如咖啡等;
③使用某些药物,如咖啡因、噻嗪类、脱水剂等;
④静脉输注液体过多,如输注生理盐水、糖盐水或其他液体等;
⑤精神紧张、癔症等,可引起暂时性、精神性多尿。而选项E:严重损伤,通常不直接导致多尿。
30、能反映骨髓造血功能的指标是( )。
A、HCTB、网织红细胞数
C、可溶性转铁蛋白受体
D、总铁结合力
E、schilling实验
【答案】B
【解析】
网织红细胞计数(尤其是网织红细胞绝对值)是反映骨髓造血功能的重要指标。。
31、患者女,32岁。第二次妊娠14周,尿液稀释250倍后,仍出现尿HCG阳性,该患者最可能是( )。
A、延期妊娠B、人工流产
C、不全流产
D、恶性葡萄胎
E、先兆流产
【答案】D
【解析】1、正确答案:D
2、答案解析:葡萄胎时滋养细胞异常增生,导致HCG水平显著升高,即使尿液稀释250倍仍呈阳性,具有重要诊断提示意义。
32、下列哪种疾病血浆纤维蛋白原含量不可能增高
A、急性肾炎B、结缔组织病
C、急性传染病
D、重症肝炎
E、急性心肌梗死
【答案】D
【解析】本题考查血浆纤维蛋白原含量在不同疾病状态下的变化。
正常情况下,血浆纤维蛋白原含量增高见于急性心肌梗死、急性传染病、结缔组织病、急性肾炎等。
然而,在重症肝炎中,由于肝脏功能受损,合成纤维蛋白原的能力下降,因此血浆纤维蛋白原含量可能降低,而不是增高。
故本题正确答案为D:重症肝炎。
33、患儿女,9岁。干咳5天,伴发热、胸痛3天,体温为38℃,双肺未闻及啰音,血常规:WBC为9×109/L,N为0.65,X线示:右下肺片状阴影,拟诊支原体肺炎,首选协助诊断的检查是
A、OT试验B、ESR
C、胸部CT
D、冷凝集试验
E、嗜异凝集试验
【答案】D
【解析】患儿女,9岁,干咳5天,伴发热、胸痛3天,血常规显示白细胞正常范围,但中性粒细胞比例略高,X线显示右下肺片状阴影,疑似支原体肺炎。
为了确诊是否为支原体感染,首选的辅助检查是冷凝集试验(D)。
该试验通过检测患者血清中的冷凝集素抗体来判断,通常在支原体感染后2周,约2/3的患者会出现阳性结果,且滴度升高有助于诊断。
其他选项如OT试验(结核菌素试验)、ESR(血沉率)、胸部CT和嗜异凝集试验,虽然在某些情况下可用于辅助诊断,但在诊断支原体肺炎时,冷凝集试验更为直接和特异性。
34、丙型病毒性肝炎抗体阳性时,下列哪一种说法是错误的
A、可变为慢性肝炎或肝硬化B、与肝癌无关
C、没有保护性
D、表示已HCV感染过
E、可进一步做HCV-RNA检测
【答案】B
【解析】1、正确答案:B
2、答案解析:丙型肝炎病毒(HCV)感染后,抗-HCV阳性表示曾有HCV感染,但无中和作用,不具保护性。
HCV易慢性化,可进展为慢性肝炎、肝硬化,并与原发性肝癌密切相关。
确诊需检测HCV-RNA以判断病毒复制情况。
35、珠蛋白分子结构异常称为
A、α地中海贫血B、β地中海贫血
C、血红蛋白病
D、PNH
E、蚕豆病
【答案】C
【解析】血红蛋白病是由于血红蛋白分子结构异常(异常血红蛋白病),或珠蛋白肽链合成速率异常(珠蛋白生成障碍性贫血,又称海洋性贫血)所引起的一组遗传性血液病。临床可表现溶血性贫血、高铁血红蛋白血症或因血红蛋白氧亲和力增高或减低而引起组织缺氧或代偿性红细胞增多所致紫绀。
36、在普通培养基上能产生非水溶性灵菌红素的细菌是
A、伤寒沙门菌B、黏质沙雷菌
C、宋内志贺菌
D、肺炎克雷伯菌
E、产气肠杆菌
【答案】B
【解析】黏质沙雷菌能够在普通培养基上产生非水溶性的灵菌红素。
(37~38为共用备选答案)
A、代谢性酸中毒B、代谢性碱中毒
C、呼吸性酸中毒
D、呼吸性碱中毒
E、代偿性呼吸性碱中毒
37、阴离子间隙是判断何种酸碱平衡紊乱的指标
【答案】A【解析】阴离子间隙(AG)主要用于评估代谢性酸中毒的严重程度和类型。
当AG值升高时,提示存在代谢性酸中毒,这可能由多种原因引起,包括但不限于肾功能不全导致的氮质血症或尿毒症,以及磷酸盐和硫酸盐的潴留。
因此,阴离子间隙是诊断和监测代谢性酸中毒状态的重要指标。
38、糖尿病酮症会引起
【答案】A【解析】糖尿病酮症会引起代谢性酸中毒。
这是由于体内产生了大量酮体,这些酮体进入血液导致酸中毒。
在代谢性酸中毒中,通常会有一系列调节机制,包括肺部通过加速呼吸来排出二氧化碳,以及肾脏通过调节来增加碳酸氢盐的重吸收。
在糖尿病酮症的情况下,如果酸性产物持续增加,超过了肺和肾的调节能力,可能导致血浆pH值下降到7.35以下,形成失代偿性代谢性酸中毒。
肾脏在调节酸碱平衡中扮演着关键角色,通过H+和Na+交换、K+和Na+交换以及排出过多的酸来实现这一目的。
(39~42为共用备选答案)
A、生物学活性测定方法B、ELISA法
C、流式细胞仪分析法
D、酶联免疫斑点试验
E、分子生物学测定方法
39、不能测定细胞因子的前体分子的是
【答案】A【解析】1、正确答案:A
2、答案解析:生物学活性测定方法依赖于细胞因子与其相应受体结合后介导的生物学效应,仅能检测具有生物活性的成熟细胞因子。
而细胞因子的前体分子尚未加工修饰,缺乏生物学活性,无法诱导靶细胞产生可测反应,因此不能被该方法识别。
相比之下,ELISA法、流式细胞术、ELISPOT及分子生物学技术(如RT-PCR)均可基于抗原性或基因表达水平检测无活性的前体形式。
40、只能测定可溶性细胞因子的是
【答案】B【解析】1、正确答案:B
2、答案解析:ELISA法是一种酶标固相免疫测定技术,主要用于检测可溶性细胞因子。
该方法基于抗原-抗体反应,具有高特异性和敏感性,适用于多种可溶性因子的定量分析,最小检出量可达纳克甚至皮克水平。
41、可在显微镜下观察到分泌细胞因子的细胞是
【答案】D【解析】酶联免疫斑点试验,是一种酶联免疫技术。用于测定分泌特异性抗体或细胞因子的单个细胞对特异性抗原的应答能力,及产生应答的细胞数量。
42、可检测细胞因子基因的缺失和突变的是
【答案】E【解析】分子生物学测定方法能检测细胞因子基因的缺失和突变。
这是免疫缺陷病检验中的一种方法,用于从分子水平研究生物大分子结构与功能,以阐明生命现象的本质。
免疫缺陷病的检测是多方面的,涉及体液免疫、细胞免疫、补体和吞噬细胞等方面,采用包括免疫学方法、分子生物学方法在内的多种手段。
对于补体系统缺陷的检测,虽然涉及众多组分,但通过总补体活性、特定组分(如C1q、C4、C3和B因子)的测定以及C1抑制剂的检测,可以大致反映补体缺陷情况,并对遗传性血管神经性水肿等疾病进行最终确诊。
(43~44为共用备选答案)
A、愈小愈好B、先进设备
C、室内质控
D、在允许误差之内
E、质控试剂
43、临床实验室定量分析测定结果的误差应该是
【答案】D【解析】1、正确答案:D:在允许误差之内
2、答案解析:临床检验中,测定结果的总误差(TE)应控制在允许总误差(TEa)范围内。
只有当检测方法的TE≤TEa时,其结果才具有临床可接受性,方可用于常规检测。
44、室间质控应在下列哪项基础上进一步实施
【答案】C【解析】1、正确答案:C: 室内质控
2、答案解析:室间质控的实施必须建立在稳定的检测系统基础之上,而室内质控是保证检验过程精密度的基本手段。
只有在室内质控处于受控状态时,才能真实反映实验室的检测能力,确保室间质量评价结果的可靠性和可比性。
因此,室内质控是开展室间质评的前提条件。
(45~46为共用备选答案)
A、精密度越低B、精密度越高
C、准确度越高
D、准确度越低
E、灵敏度越高
45、对同一样本进行重复检测,测定值差别越小,说明该检测方法
【答案】B【解析】1、正确答案:B
2、答案解析:对同一样本重复检测,测定值差异越小,表明检测结果的随机误差越小,各测量值之间的符合程度越高,即精密度越高。
精密度常用标准差衡量,标准差越小,精密度越高。
故应选B。
46、某测定值越接近真值说明该检测方法
【答案】C【解析】本题考查准确度的概念及其与测定值接近真值的关系。
准确度(accuracy)是指测量结果与真值的一致程度,即测定值越接近真值,说明该检测方法的准确度越高。
选项C正确。
精密度(precision)则指的是多次测量结果之间的一致性,与本题场景不符。
因此,正确答案是C:准确度越高。
(47~49为共用备选答案)
A、机体存在自身抗体B、直接损伤造血干细胞
C、造血干细胞功能障碍
D、粒细胞被脾脏滞留、吞噬
E、内毒素抑制骨髓释放粒细胞
47、脾功能亢进白细胞减少的机制是( )。
【答案】D【解析】
脾功能亢进:如门脉性肝硬化、班替综合征。机制为脾脏单核吞噬细胞系统破坏白细胞,或肿大脾脏分泌过多脾素,灭活促粒细胞生成因子。
48、再生障碍性贫血白细胞减少的机制是( )。
【答案】C【解析】
再生障碍性贫血概念与发病机制
(1)概念:是由多种原因致造血干细胞减少和/或功能异常,从而引起红细胞、粒细胞、血小板减少的一种获得性疾病。临床表现为贫血、感染和出血。
(2)发病机制:与造血干细胞受损、造血微环境损伤及免疫介导因素有关。
49、自身免疫性疾病白细胞减少的机制是( )。
【答案】A【解析】自身免疫性疾病导致的白细胞减少主要机制是机体存在自身抗体。
自身免疫性粒细胞减少是自身抗体、T淋巴细胞或自然杀伤细胞作用于粒系分化的不同阶段,致骨髓损伤,粒细胞生成障碍。
(50~51为共用备选答案)
A、邻苯二胺B、四甲基联苯胺
C、ABTS
D、对硝基苯膦酸酯
E、4-甲基伞酮-β-D-半乳糖苷
50、ELISA试验中碱性磷酸酶的底物是
【答案】D【解析】在ELISA试验中,碱性磷酸酶(AP)的底物通常选用对硝基苯膦酸酯(pNPP)。
当AP催化pNPP反应后,会生成黄色的对硝基酚,通过向溶液中加入NaOH终止反应并测量最大吸收峰波长为405nm,可以检测出底物转化的量,进而评估样品中目标抗原的浓度。
51、β-半乳糖苷酶的底物是
【答案】E【解析】β-半乳糖苷酶(β-Gal)的底物是4-甲基伞酮-β-D-半乳糖苷(4-MUU)。
当β-Gal作用于4-MUU时,会生成具有高强度荧光性的4-甲基伞酮(4-MU),相较于其他酶如HRP,该反应的敏感性更高,达到30~50倍。
然而,检测4-MU需要使用荧光计。
因此,正确答案是E:4-甲基伞酮-β-D-半乳糖苷。
(52~53为共用备选答案)
A、结核分枝杆菌B、痢疾志贺菌
C、淋病奈瑟菌
D、霍乱弧菌
E、副溶血性弧菌
52、通过空气传播的是
【答案】A【解析】1、正确答案:A:结核分枝杆菌
2、答案解析:结核分枝杆菌主要经呼吸道传播,通过吸入含菌飞沫或尘埃导致肺部感染,是肺结核的主要病因。
该途径为其最主要的传播方式,符合空气传播特征。
53、通过性接触传播的是
【答案】C【解析】解析:淋病奈瑟菌(选项C)通过性接触传播,是淋病的病原菌,主要感染泌尿生殖道、口咽部及肛门直肠的黏膜。
(54~55为共用备选答案)
A、桥本甲状腺炎B、胰岛素依赖性糖尿病
C、SLE
D、类风湿关节炎
E、原发性胆汁性肝硬化
54、抗dsDNA抗体与下列哪种疾病最相关
【答案】C【解析】对疑为SLE的患者,应先进行ANA和抗dsDNA抗体的检测,当ANA和/或抗dsDNA抗体阳性时,再作抗ENA抗体谱的检测,如有抗Sm抗体和/或抗RNP抗体阳性,可实验室诊断为SLE。
55、与抗线粒体抗体最相关的疾病是
【答案】E【解析】与抗线粒体抗体最相关的疾病是原发性胆汁性肝硬化(PBC)。
AMA-M2型在PBC患者中的阳性率高达98%,尤其当其效价高时,诊断特异性可达到97%。
因此,AMA检测对于诊断PBC具有高度特异性和敏感性。
(56~57为共用备选答案)
A、过失误差B、随机误差
C、比例系统误差
D、方法学误差
E、恒定系统误差
56、重复性试验是考查候选方法的
【答案】B【解析】重复性试验主要用来评估候选方法的随机误差。
在相同条件下多次测量同一样本时,结果之间会存在差异,这些差异主要由随机因素造成,即随机误差。
通过重复性试验,可以量化这种误差,帮助评估候选方法的可靠性与精确度。
57、干扰试验中加入干扰物形成的误差是
【答案】E【解析】在干扰试验中,加入的干扰物形成的误差属于恒定系统误差。
这是因为干扰物以固定的方式影响分析物的测量结果,导致每次测量都出现同样的偏差,而非随机变化或偶然性导致的误差。
(58~60为共用题干)
患儿,女,5岁。白细胞分析结果:白细胞总数23.7×109/L,中性分叶核粒细胞0.57,中性杆状核细胞0.08,淋巴细胞0.30,嗜酸性粒细胞0.03,单核细胞0.02。部分中性粒细胞胞浆中可见圆形或云雾状,界限不清,染为灰蓝色,直径1~2μm的区域。
58、判断该患者白细胞数量是否正常所应用的参考范围为( )。
A、(4~10)×109/LB、(5~12)×109/L
C、(11~12)×109/L
D、(15~20)×109/L
E、(11~15)×109/L
【答案】B
【解析】1、正确答案:B
2、答案解析:儿童外周血白细胞计数的参考范围为(5~12)×109/L,该患儿白细胞总数升高,提示存在感染或应激反应。
59、中性粒细胞胞质中出现的是( )。
A、中毒颗粒B、空泡
C、棒状小体
D、杜勒体
E、嗜碱性颗粒
【答案】D
【解析】1、正确答案:D:杜勒体
2、答案解析:在严重感染、中毒等毒性条件下,中性粒细胞可出现多种形态学改变。
题干描述的胞质内灰蓝色、圆形或云雾状、界限不清、直径1~2μm的区域,符合Dohle体特征,其为中性粒细胞胞质因毒性变而残留的嗜碱性区域,亦可出现在单核细胞中。
该表现提示细胞在应激状态下RNA局部聚集或核糖体残存。
60、患者白细胞分类计数显示为( )。
A、正常血象B、急性粒细胞白血病改变
C、慢性粒细胞白血病改变
D、毒性改变,中性粒细胞中度核右移
E、毒性改变,中性粒细胞轻度核左移
【答案】E
【解析】1、正确答案:E
2、答案解析:该患儿白细胞总数升高至23.7×109/L,中性粒细胞比例增高,其中杆状核粒细胞占8%,超过正常值(>5%),提示存在核左移。
结合部分中性粒细胞胞浆内可见中毒性改变(如灰蓝色、云雾状区域,即毒性颗粒或杜勒小体样改变),表明机体存在急性感染伴粒细胞毒性反应。
根据核左移分度标准,杆状核>5%且未见晚幼粒细胞,符合轻度核左移特征。
因此,本例为毒性改变伴中性粒细胞轻度核左移,常见于急性细菌感染。
(61~63为共用备选答案)
A、呼吸道合胞病毒B、EB病毒
C、脊髓灰质炎病毒
D、CMV
E、人乳头瘤病毒
61、与鼻咽癌密切相关的病毒是
【答案】B【解析】EB病毒与鼻咽癌的密切关系在于,EB病毒是导致鼻咽癌的主要原因之一。
在青春期发生原发感染时,病毒主要侵犯B细胞,并与包括鼻咽癌在内的多种疾病相关联。
因此,当面临选择与鼻咽癌密切相关的病毒时,正确答案应为B: EB病毒。
62、可引起<6月龄婴儿肺炎的病毒是
【答案】A【解析】1、正确答案:A:呼吸道合胞病毒
2、答案解析:呼吸道合胞病毒属副黏病毒科肺病毒亚科,是婴幼儿下呼吸道感染最常见的病原体。
主要通过飞沫传播,易引发<6月龄婴儿的细支气管炎和细支气管肺炎,病情进展快,死亡率较高。
年长儿及成人多表现为上呼吸道感染。
63、能致胎儿宫内感染的病毒是
【答案】D【解析】CMV(巨细胞病毒)能够导致胎儿宫内感染。
在妊娠期间,如果母亲发生CMV感染,病毒可以通过胎盘传播给胎儿,引起宫内感染。
因此,正确答案是D: CMV。
(64~65为共用备选答案)
A、裂片细胞B、杜勒小体
C、卡波环
D、染色质小体
E、嗜多色性红细胞
64、弥散性血管内凝血易见增多的细胞是
【答案】A【解析】弥散性血管内凝血(DIC)时,红细胞形态改变可见裂片细胞增多。
裂片细胞是指大小不一、外形不规则的红细胞碎片,常见于DIC、微血管病性溶血性贫血、肾小球肾炎、尿毒症等疾病。
在弥散性血管内凝血过程中,红细胞通过阻塞的、管腔狭窄的微血管而发生破碎,形成裂片细胞。
因此,本题答案选A:裂片细胞。
65、溶血性贫血易见增多的细胞是
【答案】E【解析】在溶血性贫血的背景下,易见增多的细胞是嗜多色性红细胞。
这些细胞实质上是网织红细胞,其特征在于细胞内存在不同阶段的染色体着色,表明它们处于成熟过程的不同阶段。
在溶血性贫血中,尤其是自身免疫性溶血性贫血,这种类型的红细胞增多较为显著,反映了骨髓对贫血状态的快速反应,试图增加红细胞生成以补偿受损或破坏的红细胞。
(66~67为共用备选答案)
A、质量文件的核心B、质量手册的核心
C、程序性文件的核心
D、操作规程的核心
E、质量记录的核心
66、及时性和真实性是
【答案】E【解析】及时性和真实性是质量记录的核心。
质量记录作为质量体系运行的有效性依据,主要用于证明质量体系运行的结果,以及执行活动的证据。
它们反映了实验室内部或外部的质量活动情况,是确保质量体系正常运作的关键文档。
67、质量方针、目标、组织机构及质量管理体系要素的描述是
【答案】B【解析】质量手册的核心内容主要包括:
1. 质量方针目标:阐述实验室的质量承诺和具体质量目标,确保所有员工理解和执行。
2. 组织机构:明确实验室内部各部门的职责、权限以及相互间的接口与联系方式,确保质量管理的有效实施。
3. 质量管理体系要素描述:详细说明质量管理体系的组成部分,包括管理、执行和验证等关键职能,以及各部分之间的相互作用。
这些核心内容共同构成了质量手册的基础框架,旨在规范和指导实验室的质量管理实践,确保提供符合要求的检测服务。
(68~70为共用备选答案)
A、镧系元素铕螯合物B、鲁米诺
C、AMPPD
D、吖啶酯
E、对硝基苯酚
68、化学发光免疫分析中,目前常用的直接标记发光剂是
【答案】D【解析】1、正确答案:D:吖啶酯
2、答案解析:在化学发光免疫分析中,直接标记发光剂需具备可直接参与发光反应且能共价标记抗原或抗体的特性。
传统直接发光剂包括鲁米诺与吖啶酯,但前者多用于酶促发光体系,而吖啶酯因具有高灵敏度、稳定性好及无需催化剂即可发光等优势,成为目前最常用的直接化学发光标志物。
69、微粒子化学发光免疫分析的发光底物是
【答案】C【解析】1、正确答案:C: AMPPD
2、答案解析:微粒子化学发光免疫分析中,碱性磷酸酶催化AMPPD水解,生成不稳定的中间体,其分解时二氧四节环断裂并释放光子,产生持续性化学发光。
该反应具有高灵敏度和稳定性,故AMPPD为该体系的关键发光底物。
70、时间分辨荧光免疫分析的标记物是
【答案】A【解析】时间分辨荧光免疫分析的标记物是镧系元素铕螯合物。
此技术通过利用镧系元素的长荧光寿命和强荧光特性,结合时间分辨技术来检测抗原抗体复合物中的特异性荧光强度,从而实现对微量或超微量物质的定量测定。
相较于其他荧光免疫分析方法,时间分辨荧光免疫分析具有较高的灵敏度和特异性,有效减少了非特异性荧光的干扰。
(71~72为共用备选答案)
A、HAVB、HSV
C、HCMV
D、HIV
E、HPV
71、不会通过母婴途径传播的RNA病毒是
【答案】A【解析】1、正确答案:A: HAV
2、答案解析:HAV为RNA病毒,主要经粪-口途径传播,不会通过母婴垂直传播。
而HIV虽同为RNA病毒,但可通过胎盘、产道或哺乳等母婴途径传播;
HSV、HCMV和HPV为DNA病毒,亦可经母婴传播。
因此,不通过母婴传播的RNA病毒为HAV。
72、通过性接触传播的RNA病毒是
【答案】D【解析】HIV是通过性接触传播的RNA病毒。
(73~74为共用备选答案)
A、波峰右移,峰底变宽B、波峰左移,峰底变宽
C、波峰右移,峰底不变
D、波峰左移,峰底不变
E、直方图不变
73、轻型B-血红蛋白合成障碍的直方图表现为( )。
【答案】D【解析】
轻型B-血红蛋白合成障碍红细胞主峰左移,分布在55~100fl,波峰在75fl处,峰底不变。RDW正常:红细胞主峰左移,分布在55~100fl,波峰在75fl处,基底较窄,为小细胞低色素均一性图形,见于轻型地中海贫血。
74、缺铁性贫血的直方图表现为( )。
【答案】B【解析】缺铁性贫血时,直方图特征表现为红细胞主峰左移,同时峰底变宽。
RDW轻度增高:红细胞主峰左移,分布在55~100fl,波峰在65fl处,为小细胞低色素和细胞不均一性图形,见于缺铁性贫血。
75、肾间质性肾炎尿成分主要是( )。
A、红细胞B、白细胞
C、蛋白质
D、血小板
E、管型
【答案】C
【解析】1、正确答案:C
2、答案解析:肾小管受损导致蛋白质重吸收障碍,引起以蛋白尿为主要表现的尿液成分改变。
(76~77为共用备选答案)
A、MCV正常,MCH正常,MCHC正常B、MCV>正常,MCH>正常,MCHC正常
C、MCV>正常,MCH>正常,MCHC>正常
D、MCV<正常,MCH<正常,MCHC<正常
E、MCV<正常,MCH<正常,MCHC正常
76、急性失血的血常规表现( )。
【答案】A【解析】解析:急性失血导致的血常规表现为正细胞性贫血,即MCV、MCH、MCHC均在正常范围内。
77、重型珠蛋白生成障碍性贫血的血常规表现( )。
【答案】D【解析】小细胞低色素性贫血:MCV降低、MCH降低、MCHC降低,见于铁缺乏、维生素B6缺乏、珠蛋白生成障碍性贫血、慢性失血等。
(78~79为共用题干)
患儿男,3岁。发育迟缓。记忆力及智商水平低下,性格多变,易激怒。实验室检查:贫血,白细胞计数减少,血小板正常,血象如下图所示。

78、图中箭头指示的细胞为( )。
A、嗜碱性点彩红细胞B、红细胞内豪焦小体
C、有核红细胞
D、红细胞内寄生虫
E、含卡波环红细胞
【答案】A
【解析】
红细胞内出现异常结构包括①嗜碱性点彩红细胞:瑞氏染色后,胞质内出现形态不一的蓝色颗粒(变性RNA),颗粒大小不一、多少不等。见于铅中毒、正常人(约占l/10000);②豪焦小体:成熟红细胞或幼红细胞胞质内含有一个或多个直径为l~2μm暗紫红色圆形小体,为核碎裂、溶解后的残余部分;③卡波环:在嗜多色性、碱性点彩红细胞胞质中出现紫红色细线圈状结构,呈环形、8字形,为核膜残余物、纺锤体残余物、脂蛋白变性物。
79、该患儿最可能的诊断是( )。
A、缺铁性贫血B、病毒感染
C、细菌感染
D、再生障碍性贫血
E、重金属中毒
【答案】E
【解析】
嗜碱性点彩红细胞原因为重金属损伤细胞膜,使嗜碱性物质凝集,或使嗜碱性物质变性,或血红蛋白合成中原卟啉与铁结合受阻。见于铅中毒。
(80~81为共用题干)
患者男,58岁。体检:心肺(-)。X线检查未见异常。实验室检查:血清K+ 3.6mmol/L,Na+ 142mmol/L,Ca2+ 2.95mmol/L,P 1.05mmol/L,BUN 6.5mmol/L,ALB 45g/L,ALP 72U/L。
80、该患者检查结果表现为( )。
A、高钙血症B、低钙血症
C、高磷血症
D、低磷血症
E、低钾血症
【答案】A
【解析】1、正确答案:A
2、答案解析:血清Ca²⁺正常参考范围为2.25~2.75mmol/L,该患者检测值为2.95mmol/L,高于上限,提示存在高钙血症。
81、下一步应做的检查是( )。
A、血清PTHB、血F3T4
C、血17-羟
D、血NE
E、血5-HT
【答案】A
【解析】
与钙浓度调节有关的因素包括PTH、CT、1,25-(OH)2-D3等,其中最重要的是PTH,因此进一步检查应选择PTH。甲状旁腺激素:是维持血钙正常水平最重要的调节因素,有升高血钙、降低血磷和酸化血液等作用。
(82~83为共用备选答案)
A、梅毒螺旋体B、钩端螺旋体
C、伯氏疏螺旋体
D、雅司螺旋体
E、回归热疏螺旋体
82、引起莱姆病的主要病原体是
【答案】C【解析】莱姆病由伯氏疏螺旋体引起,主要通过硬蜱叮咬传播,临床表现包括移行性红斑、关节炎、神经系统或皮肤异常等。
未及时治疗可导致晚期慢性症状。
83、对理化因素抵抗力最弱的病原性螺旋体是
【答案】A【解析】梅毒螺旋体对理化因素的抵抗力最弱,包括对温度、干燥、化学消毒剂(如苯酚、青霉素、四环素等)的敏感性高,在外环境中的存活时间极短,通常数分钟内即死亡。
因此,正确答案为A:梅毒螺旋体。

